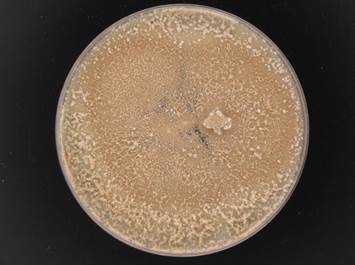
Wuxi Biologics signs R&D license for fungal expression tech Wuxi Biologics signs R&D license for fungal expression tech

Content Spotlight
Podcast: MilliporeSigma says education vital to creating unbreakable chain for sustainability
MilliporeSigma discusses the importance of people, education, and the benefits of embracing discomfort to bolster sustainability efforts.
March 31, 2020
Wuxi Biologics is testing a gene expression system that Dyadic International claims is faster and more efficient than competing systems.
Dyadic shared details of the non-exclusive research license on March 30, explaining the Chinese contract development and manufacturing organization (CDMO) will evaluate the C1 technology and cell lines in a cGMP environment.
The deal was confirmed by Wuxi Biologics spokesman Kevin Huang, who told us “This is to initiate a test of their C1 strain for microbial protein expression.”

Dyadic’s C1 system is based on the fungus Myceliophthora thermophila
He added, “If successful, this will be complimentary to our existing technical platforms and would enable our partners for biologics development. At current stage, we are not able to disclose other details including testing metrics.”
The deal comes a few months after Wuxi Biologics said it would use the proceeds of a recent funding round – some HK$3,950 million ($500 million) – to establish fermentation-based manufacturing capacity.
Wuxi said it “intends to apply the net proceeds from the Primary Placing to support its development of vaccines and microbial based products as well as continuous global capacity expansion.”
At the time the firm told us it would set up an integrated innovation center for new biologics technology platforms including microbial in Hangzhou, Zhejiang province, China.
Dyadic’s tech is based on Myceliophthora thermophila, a fungus that encodes a number of enzymes that retain their function at high temperatures. The organism is widely used in industry, specifically in cellulose degradation and biofuel production
According to Dyadic the C1-based protein expression system can produce yields of up to 80 grams per liter, which is significantly higher than conventional expression systems.
Wuxi is not the only manufacturer assessing the technology. Last year, Dyadic agreed deals with Luina Bio, Alphazyme, and the Serum Institute of India.
In 2018, Sanofi signed an R&D agreement for the technology. At the time Dyadic said Sanofi would use the C1 platform to overcome gene expression challenges across some of its vaccine and protein-based biologics.
Related stories: Encroaching titer, hidden danger: Upstream intensification and the downstream mess
You May Also Like